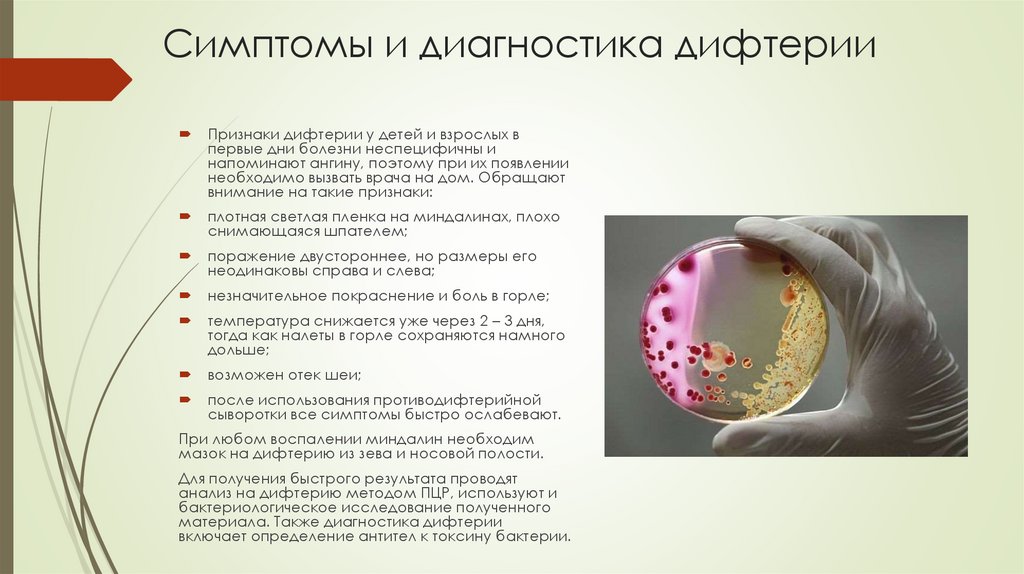

Похожие презентации:
Появление дифтерии в России
1.
«Дифтерия»ГУЗ ОКОД г.Ульяновска
2.
Дифтерия , что это и распространениеДифтерия – острая антропонозная
бактериальная инфекция с
общетоксическими явлениями и
фибринозным воспалением в месте
входных ворот возбудителя. Ранее это
заболевание было распространено у детей
и сопровождалось высокой смертностью.
Только 95% иммунизация населения
привела к тому, что сейчас наблюдаются
лишь единичные случаи болезни. Все чаще
регистрируются симптомы дифтерии у
взрослых и подростков, что связано с
постепенным ослаблением
приобретенного после вакцинации
иммунитета.
3.
Открытие дифтерии и вклад учёных визучение заболевания
Фридрих
Лёффлер
Эдвин Клебс
Возбудитель Дифтерийная палочка — грамположительные палочковидные
бактерии рода Corynebacterium. Впервые возбудитель был обнаружен на
срезах плёнок, полученных из ротоглотки больных в 1883 г. Эдвином
Клебсом.
Лёффлер первым выделил бактерию дифтерии в чистом виде и смог
культивировать ее для дальнейших исследований: ведь в пленках с гортани
больных было полно и других бактерий, обитающих в норме на слизистой
горла. И именно Лёффлер именно на бацилле дифтерии и морской
свинке показал правоту так называемых четырех постулатов Коха:
Микроорганизм постоянно встречается в организме больных людей (или
животных) и отсутствует у здоровых;
Микроорганизм должен быть изолирован от больного человека (или
животного) и его штамм должен быть выращен в чистой культуре;
При заражении чистой культурой микроорганизма здоровый человек (или
животное) заболевает;
Микроорганизм должен быть повторно изолирован от экспериментально
заражённого человека (или животного).
Часто пишут, что первый ход в длинной и запутанной партии человечества
против дифтерии сделал немецкий бактериолог Фридрих Лёффлер,
первооткрыватель возбудителя сапа. В 1884 году он сумел открыть
бактерии, вызывающие дифтерию — палочки Corynebacterium
diphtheriae. На самом деле, это не так, и не зря другое название
бактерии – бацилла Клебса-Лёффлера. Еще за год до своего
соотечественника в дифтеритных пленках бактерию обнаружил другой
выдающийся немец, Эдвин Клебс.
4.
Появление дифтерии в РоссииВ XVIII веке дифтерия появилась в Англии, Германии, Голландии, Швейцарии,
Северной Америке. С первой половины XIX века эпидемии дифтерии
регистрировались почти во всех странах мира с высокой детской смертностью.
Предполагают, что в Россию дифтерия была занесена из Румынии сначала в
северные, затем в южные губернии.
5.
Возбудители дифтерии, какпроисходит заражение
Возбудитель дифтерии – микроорганизм из рода коринебактерий. При
размножении он выделяет во внешнюю среду токсин. Это сильнодействующее
вещество определяет местную реакцию и системные признаки дифтерии.
Однако не все дифтерийные палочки способны к выделению токсина.
Микроорганизм сохраняется на окружающих предметах до 2 недель,
выживает при кипячении менее 1 минуты. Основные пути инфицирования –
воздушно-капельный и контактно-бытовой. Наиболее заразны больные, но
коринебактерии могут выделять в окружающую среду и внешне здоровые
носители микроорганизмов. Именно носители сейчас являются основными
источниками инфицирования, причем чаще всего это дети с хроническими
ЛОР-заболеваниями.
Симптомы дифтерии зависят от места попадания микроба в организм. Чаще
всего это зев, трахея, нос, глаза, кожа и слизистая оболочка наружных половых
органов. После попадания возбудителя начинается инкубационный период,
длящийся от 2 до 12 дней, в его конце больной становится заразным.
6.
Токсин дифтерииCorynebacterium diphtheriae обычно поражают
носоглотку (респираторная дифтерия) либо
кожные покровы (кожная дифтерия).
Штаммы дифтерии, инфицированные бетафагом, содержащим токсин-кодирующий ген,
продуцируют мощные токсины. Этот токсин
сначала вызывает воспаление и некроз
локальных тканей, а затем может оказать
воздействие на сердечно-сосудистую,
нервную и мочевыделительную системы.
Corynebacterium diphtheriae (лат.) — вид
грамположительных палочковидных бактерий
рода коринебактерий (Corynebacterium),
Нетоксигенные штаммы C. diphtheriae могут
возбудитель дифтерии. Впервые описана
также вызывать носоглоточную инфекцию и
немецким микробиологом Эдвином Клебсом,
иногда системное заболевание (например,
выделена в чистую культуру немецким врачом и
эндокардит, септический артрит).
микробиологом Фридрихом Лёффлером.
7.
Симптомы дифтерииНаиболее характерные признаки дифтерии:
пленка на поверхности тканей, плотно спаянная с ними;
увеличение лимфоузлов, повышение температуры;
легкая боль при глотании;
головная боль, слабость, симптомы интоксикации;
реже отек и выделения из носа, глаз.
Дифтерия зева – самая распространенная форма
заболевания. Она может иметь разную степень
тяжести:
Локализованная
Начинается с повышения температуры в течение 3 дней,
недомогания. На 2-е сутки на миндалинах появляются
налеты, сохраняющиеся в течение недели.
Подчелюстные узлы незначительно увеличены.
Распространенная
Дифтерийные налеты распространяются на язычок, небо, ротоглотку.
Токсическая
Развивается быстро с повышения температуры до 40˚С, боли в горле, отека подкожной
клетчатки на шее (отличительный признак этой формы). Пленки плотные, пропитаны кровью,
имеют сладковатый запах, распространяются по всей носоглотке.
Молниеносная
8.
СимптомыВ течение нескольких часов резко
повышается температура, появляется рвота,
судороги, наступает потеря сознания,
снижение артериального давления, угнетение
работы сердца, кровоизлияния под кожу.
Дифтерийные пленки не успевают
сформироваться, так как в ближайшие 2 – 3
дня наступает гибель больного.
Симптомы дифтерии у детей до 5 лет могут
проявляться в виде крупа – кашля,
усиливающегося сужения дыхательных путей
и удушья. Это угрожающее жизни состояние,
требующее немедленной медицинской
помощи.
Дифтерия у детей может возникнуть даже на
фоне иммунитета после прививки, однако
заболевание протекает легче:
развивается локализованная форма болезни;
не возникает круп;
практически отсутствуют осложнения;
вероятность развития неблагоприятного
исхода минимальна.
9.
Симптомы и диагностика дифтерииПризнаки дифтерии у детей и взрослых в
первые дни болезни неспецифичны и
напоминают ангину, поэтому при их появлении
необходимо вызвать врача на дом. Обращают
внимание на такие признаки:
плотная светлая пленка на миндалинах, плохо
снимающаяся шпателем;
поражение двустороннее, но размеры его
неодинаковы справа и слева;
незначительное покраснение и боль в горле;
температура снижается уже через 2 – 3 дня,
тогда как налеты в горле сохраняются намного
дольше;
возможен отек шеи;
после использования противодифтерийной
сыворотки все симптомы быстро ослабевают.
При любом воспалении миндалин необходим
мазок на дифтерию из зева и носовой полости.
Для получения быстрого результата проводят
анализ на дифтерию методом ПЦР, используют и
бактериологическое исследование полученного
материала. Также диагностика дифтерии
включает определение антител к токсину бактерии.
10.
Лечение дифтерииИспользование народных средств
при этом заболевании
недопустимо. Лечение дифтерии
проводится только в инфекционной
больнице, в изолированном боксе.
Промедление с госпитализацией
может стать причиной осложнений
и неблагоприятного исхода
болезни.
В терапии используется
противодифтерийная сыворотка,
антибиотики, общеукрепляющая
терапия.
Госпитализации подлежат и
выявленные во время осмотров
носители токсигенных штаммов
(вариантов) возбудителя. Им
назначается антибиотикотерапия.
11.
ПрофилактикаСоздание искусственного иммунитета
против болезни – наиболее
эффективная профилактика дифтерии.
Первая прививка от дифтерии
проводится в 3-месячном возрасте
ребенка вакциной АКДС или АДС.
Затем ее повторяют в 4,5 месяца,
полгода, 1,5 года и 6 лет. Ревакцинация
дифтерии проводится начиная с 16летнего возраста один раз каждые 10
лет. Кроме отечественных препаратов,
доступна импортная вакцина от
дифтерии – аналог АКДС Инфанрикс
или АДС – Т. Д. Вакс.
Дополнительные меры профилактики:
исследование мазков из носоглотки у
всех контактировавших с заболевшим
человеком;
медицинское наблюдение за
контактировавшими людьми в течение
недели;
дезинфекция в помещении после
госпитализации больного.
12.
Осложнения дифтерииРазвитие осложнений возможно
при любой, даже легкой форме
заболевания. К ним относятся:
воспаление сердечной мышцы –
миокардит;
поражение нервной системы –
параличи лицевых мышц,
дыхательной мускулатуры,
конечностей;
поражение почек с развитием
нефротического синдрома;
при тяжелом течении болезни
возможен инфекционнотоксический шок.

Медицина
Медицина








